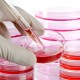

O futuro da Cirurgia Plástica
25 de março de 2016
Abdominoplastia, Miniabdome, Lipoabdominoplastia.
25 de março de 2016Há alguns meses, as notícias sobre Andressa Urach, a modelo e apresentadora de 27 anos, ganharam espaço na TV, revistas e jornais. A modelo, conhecida pelas curvas acentuadas, especialmente coxas e glúteos para lá de “modelados”, apresentou um quadro de infecção nas coxas, justamente nos locais onde havia recebido injeções do produto Hidrogel em grande quantidade, há 5 anos, segundo informações de sua assessoria. Mas afinal, o que ocorrera de fato? Este produto “causa” infecção nas pessoas? Só o preenchimento na coxa é perigoso? Ou qualquer preenchimento? No rosto também ou somente no corpo? Essas são umas das dúvidas que pairam sobre as mentes das pessoas que sonham com um corpo perfeito e pensam em ir além da academia.
Mas vamos lá: há muitos pontos a serem esclarecidos. A coisa não é tão simples assim, e há muito mais nuances entre o “preenchimento estético” e o “risco de morte” do que a obviedade de raciocínios mais simplistas.
O Hidrogel é um produto considerado biocompatível, usado em todo o mundo para preenchimento facial e corporal. É um produto de “longa duração”, o que significa que após injetado no organismo, permanece onde foi injetado por muitos anos, em alguns casos para sempre, podendo ficar resíduos do produto, mesmo após a maior parte de seu volume ter sido absorvido. Apesar de o produto ser considerado biocompatível, ou seja, causar respostas positivas no organismo humano, não significa que reações adversas não possam ocorrer. E se elas ocorrerem a solução é difícil tanto pela característica de “longa duração”, quanto pelo fato desse tipo de produto “segurar” bactérias e outros agentes infecciosos e dificultar a chegada de antibióticos ao local onde foram injetados. As conseqüências disso podem ser muito graves.
Para que um produto seja aceito para ser usado como preenchedor, os laboratórios precisam realizar estudos científicos que comprovem sua eficácia e também sua segurança. O Hidrogel, portanto, é bastante estudado pela comunidade científica, e seu uso é aprovado em vários países do mundo, inclusive no Brasil, pela ANVISA (Agencia Nacional de Vigilância Sanitária). Segundo o site da ANVISA, a licença de comercialização do Hidrogel está vencida desde o dia 29 de dezembro de 2013, o que torna seu uso após essa época sujeito a penalidades. Mas até essa data, o órgão admitia seu uso até o limite de 50 ml em qualquer região do corpo. Já a Sociedade Brasileira de Cirurgia Plástica, SBCP, órgão que dita normas de conduta de seus membros quanto a procedimentos estéticos e cirúrgicos, não recomenda o uso do produto. Principalmente pelo fato de os estudos científicos de longo prazo serem inconclusivos.
No caso de Andressa, sua assessoria informou que a aplicação do Hidrogel nas coxas foi há 5 anos, em uma clínica privada de São Paulo, e o volume aplicado foi cerca de 400 ml. Informou ainda que anteriormente a modelo também havia sido submetida a uma aplicação de “PMMA”, polimetilmetacrilato, na mesma região – outro produto definitivo, ou seja, inabsorvível.
Mas o que de fato ocorreu após 5 anos do procedimento? As complicações possíveis são necrose, infecção, septicemia, embolia e deformidades estéticas pelo comportamento imprevisível em longo prazo. O quadro específico de Andressa pode ter se agravado pelo fato dela ter usado duas substâncias: PMMA e Hidrogel. E em grande quantidade – cerca de 400 ml segundo notas da imprensa. Sabemos que tanto o Hidrogel quanto o “PMMA” podem causar reações adversas mesmo após anos da aplicação, e que a gravidade das mesmas é proporcional ao volume injetado e relacionada à forma como foi feito o procedimento, à qualidade do produto injetado e a condições individuais do próprio sistema imune do paciente. Mais uma vez, caímos na complexidade da medicina e do organismo humano, o qual deve ser tratado com respeito, com cautela e principalmente segundo normas de segurança.
Segundo dados da imprensa e notas oficiais, a modelo apresentou fortes dores nas coxas e sinais inflamatórios onde os produtos foram injetados. O quadro que se seguiu foi de infecção localizada, depois generalizada, com drenagem de secreção purulenta pelos orifícios de supuração e pelos locais de incisão feitos pelos médicos, no intuito de drenar o material infectado e controlar a infecção generalizada. Foi também necessário o uso de antibióticos venosos e locais e também a internação em unidade de terapia intensiva (UTI), para que todo o quadro pudesse ser adequadamente controlado. Quanto à retirada dos produtos, o “PMMA” se fixa aos tecidos, sendo muito difícil ou impossível removê-lo e conseqüentemente tratar uma infecção relacionada a ele. Como o produto entremeia-se aos músculos onde é injetado, muitas vezes, controlar o processo envolve retirar partes da musculatura. No caso do “Hidrogel”, é mais fácil retirá-lo, mas não totalmente, podendo haver resquícios que perpetuam a infecção.
Caso a modelo consiga se recuperar deste quadro, e esperamos que sim, as seqüelas menos graves serão cicatrizes, por onde o produto e o pus foi drenado, um volume bem menor nas coxas, devido à própria perda do produto, depressões causadas pela retirada de partes da musculatura atingida e uma triste história para contar de um período em que esteve literalmente entre a vida e a morte.
As explicações científicas sobre ambos os produtos estão no quadro ao lado bem como os mecanismos pelos quais as complicações podem ocorrer.
Não me canso de repetir de que se sentir bem com o próprio corpo ou desejar o corpo perfeito é algo compreensível e legítimo, mas zelar pela própria vida e cuidar do corpo físico de uma forma responsável é obrigação.
O caso “Andressa” chamou a atenção de todos, para os perigos envolvidos em lidar com o corpo humano, e também para a cautela necessária no ato médico.
Cabem a nós, médicos, ponderar neste ato, educar nossos pacientes e dizer “não” a contravenções das normais vigentes. A responsabilidade é nossa sim, médicos, detentores do conhecimento científico, e responsáveis pela vida e segurança do paciente.
Sobre as substâncias
O Hidrogel é um nome genérico dado a um composto de água e uma molécula sintética capaz de reter e segurar as moléculas de água. A consistência gelatinosa deste composto confere-lhe o nome: gel. Essa molécula é feita de uma substância chamada genericamente de poliamida e possui semelhança química como o plástico. Após ser introduzido no organismo, desencadeia a produção de uma cápsula ao redor dele, que o mantém por longos períodos naquele meio, ou até permanentemente. O Hidrogel é produzido na Ucrânia.
O PMMA ou polimetilmetracrilato é um composto cujas esferas têm composição química semelhante ao acrílico. As microesferas são suspensas em um veículo, que ao ser absorvido com o tempo, vai sendo substituído por um colágeno, que se forma ao redor dessas micropartículas. O produto é definitivo e não será absorvido com o tempo. O “PMMA” é produzido no Brasil e também em vários países do mundo, Europa e Estados Unidos.





